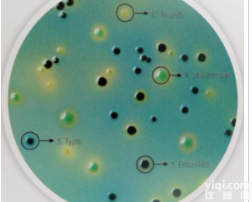
<em>沙门氏菌鉴别培养基（改良型）</em>
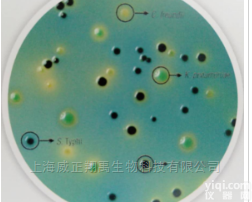
M1816  <em>沙门氏菌鉴别培养基（改良型）</em>
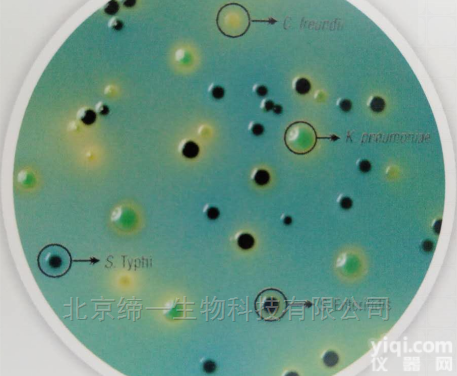
M1816  <em>沙门氏菌鉴别培养基（改良型）</em>

沙门氏菌鉴别培养基(改良型)
- 品牌:HiMedia
- 型号:M1816
- 供应商:北京缔一生物科技有限公司
- 供应商报价:询价
- 标签:沙门氏菌鉴别培养基(改良型)、沙门氏菌鉴别培养基(改良型)价格、沙门氏菌鉴别培养基(改良型)厂家、、、北京缔一生物科技有限公司
沙门氏菌鉴别培养基(改良型)
HiCrome MM Agar Modified
用途
推荐从临床样本中选择性鉴别和分离沙门氏菌和非沙门氏菌(如柠檬酸杆菌)
原理
显色液区分乳糖发酵和非乳糖发酵
存在三种糖,纤维二糖、蔗糖、木糖能刺激更好的生长
BTB是指示剂
培养结果
大肠杆菌-蓝绿色
沙门氏菌-中间黑色
柠檬酸杆菌-无色(延长孵育时间,可能为蓝绿色)
绿脓杆菌-无色
肺炎克雷伯菌-蓝绿色
| 货号/规格 | 产品名称 | 价格 |
| M1816-100G | HiCrome MM Agar Modified | 询价 |
| M1816-500G | HiCrome MM Agar Modified | 询价 |
资料下载:
沙门氏菌鉴别培养基(改良型).png 附件下载 (下载 0 次)
请 [登录] 后再下载!